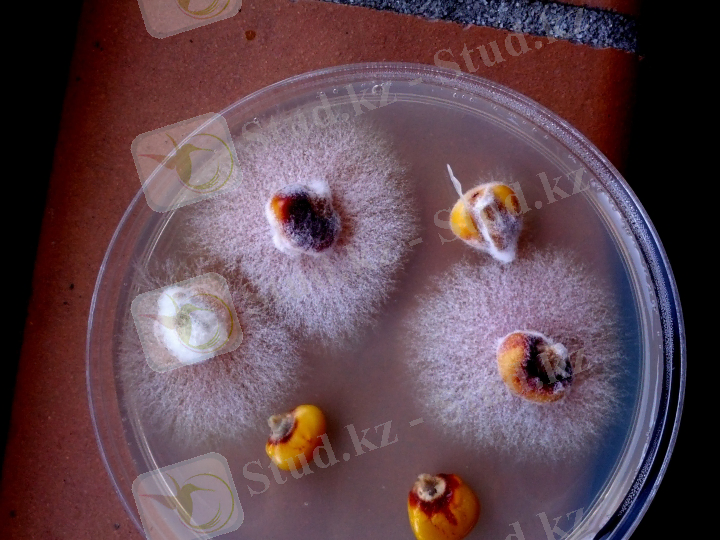
pathogenic-fungus-Fusarium-threatens-integrity-of-corn.jpg

Қоздырғыштарды зертханалық зерттеу әдістерін меңгеру және микотоксикоздар тудыратын аурулардың сипаттамасы


Жәңгір хан атындағы Батыс Қазақстан аграрлық техникалық университеті
Ветеринарлық медицина және мал шаруашылығы институты
Тақырыбы:
1. Қоздырғыштарды зертханалық зерттеу әдістерін меңгеру
2. Микотоксикоздар тудыратын ауруларға сипаттама беріңіз

Жұқпалы ауруларды індеттанулық балау әдісі Біріншіден аурудың нозологиялық балауы тез арада қойылуы қажет. Екіншіден, балау әдістері жүйелі қолданылып, инфекциянның індеттік өзіне тән ерекшеліктеріне, клиникалық, патология-анатомиялық белгілеріне баса мән беріледі. Жүйеге індеттанулық талдау, клиникалық, патоморфологиялық, бактериологиялық, вирусолгиялық, серологиялық, баяу типті сезімталдыққа негізделген аллергиялық әдіс т. б жатады. Клиникалық балау. Малдың дене қызуын өлшеуден бастау ұсынылады. Қолданылатын термометрлер тексеруден өтулері қажет және олардың дезинфекциялық ерітінділерде сақталуы шарт. ауруга тән клиникалық белгілер малбос тұрғанда айқын байқалады. Сондықтан ауру малды байламай, олардың жағдайына бақылау жүргізу керек. Бұдан кейін қажет саналса, тиісті мүшелеріне арнайы зерттеулер жүргізіледі. Клин. балау қоюда қосалқы инфекциялардың болатынына назар алынуы қажет. Клин. зерттеуге гематологялық әдіс те жатады. Бактериологиялық балау. Топалаң, пастерллез т. б жіті өршитін инфекциялық аурудың нақтылы балауы бактер. зерттеулердің нәтижесінде қойылады. Жүргізілген зерттеу нәтижесінде бактериологиялық балау расталынып, күдіктенген аурудан ажыратылады. Қажет болған жағдайда ауру қоздырғышының типі идентификацияланады. Вирусологялық зерттеуде материал алу, жіберу әдістемесі, жолдама құжат толтыру керек. Тек вирустың термолобильдігі, яғни жоғары температураға төзімділігі ескеріліп, әсіресе жаз айларында патологиялық материал мұз салынған арнайы термосқа салынып жіберіледі. серологиялық балау әдістерімен иммундыглобулин кластарын зерттеу арқылы инфекциялық процестің динамикасын анықтауға болады. Қазіргі кезде серологиялық балау эпизоотологтарға тек қана инфекциялық аурулардың, оынң ішінде әсіресе виркстық инфекциялардың нозогеографиялық таралуын ғана емес, вакциналық иммундық фонды қадағалауға кең түрде қолданылады. Серологиялық реакциялар жай, күрделі, бір, екі, үш және т. с. с компонетті, антиген немесе антидене анықтауға қолданылатын немесе лизистенуі, нейтрализациялануы, тұнбаға түсуі бойынша топтарға бөлінеді. Аллергиялық реакциялардың арасында баяу типтік сезімталдық өзіндік қасиеті бойынша ең жоғарғысы. Сондықтан оны бруцеллез, туберкулез, маңқа т. б жұқпалы ауруларды балауға кең түрде пайдаланылады.
Микотоксикоздар - микотоксиндермен адамның және жануарлардың улaнуы.
Микотоксиндер топырақта көп кездесетің фитопатогенді және сапрофитті саңырауқұлақтардың көбісімен продуцирленеді. Олармен продуцирленетің микотоксиндер жинаудың, сақтаудың және өндеудің қолайсыз жағдайларында ауылшаруашылық дақылдарында жинақталады.
Әсіресе жануар текті азықтарда микотоксиндердің анықталуына көп көніл бөлу керек(етсүтті тағамдар, жұмыртқа) . Микотоксиндер қоректін құрамында көгеру болмаса да болуы мүмкін. Жануарлардың улануы күзде және ерте көктемде болуы мүмкін. Микотоксиндер сыртқы орта факторларына төзімді болып келеді, оның ішінде суыққа, жоғары температураға, құрғатуға, ультрофиолет және ионды сәуле әсері.
Ең тараған адам мен жануардағы алиментарлы микотоксикоздардың біріей фузариотоксикоздар: , , фузарионивале-токсикоз. Қоздырғышы болып трихоцетен тобының токсиндерін продуцирлейтің Fusarium тұқымдастығына жататың саңырауқұлақтар болып саналады
1. Фузариоз . Егін далаларында Fuzarium тұқымдастығына жататын өсімдіктің тамырын, сабағын және сағағын зақымдайтың саңырауқұлақтар тудыратын ауру тараған.
Сағақтын және дәннің фузариозы ауаның ылғалдылығы және температурасы жоғары болғанда дамиды. Фузариозды дәнмен улану бұрын некротикалық ангинаға ұқсағандықтан септикалық ангина деп атаған. Негізінде зақымдалған дәннен пісірілген нанды қолданғаннан кейін 1-2 жетіден кейін қанда гранулоциттердін санының өзгеруі байқалады, ал содан соң миелоидты және лимфоидты тіндердін зақымдалуы, сүйік кемігінің некрозы байқалады, нәтижесінде қанайналым бұзылады.
Егіннің қатты сорттары, сонымен бірге вегетециялық периоды ұзарған және органогенез фазаларының ақырындауымен сипатталатың сорттар фузариозбен зақымдалуға сезімтал болып келеді. Сағақтың қабыршағы дәнге тығыз жанасқан және қатты, тығыз кутикуласы бар егін сорттары фузариозға тұрақты болып келеді.
Дәндердің токсигендігін анықтау әдісі фузариозбен зақымдалуы өнімнін төмендеуіне және адам және жануар денсаулығына қауыпты заттардын ең алдымен вомитоксиндердің жиналуына әкеледі. .
Фузариоздар деп фузариум тұқымдастығының саңырауқұлақтармен зақымдалған нан өнімдері қолдану нәтижесінде туатын алиментарлық ауру. Бұл аурудың этиологиясы толық зерттелмеген. Уланудын кең тараған түрі «пьяный хлеб» және алиментарлы-токсикалық алейкия.
«Пьяный хлеб» улануы. Fusarium тұқымдастығының саңырауқұлақтармен зақымдалған дәндердің сырт пішіні кедір бүдір және кейде аққызыл налет болады. Зақымдалған дәнде органикалық заттардын терең ыдырауы байқалады, кейбір авторлардың айтуынша оның ішінде токсикалық заттар түзіледі.
Зақымдалған дәннен піскен нан «пьяный хлеб» деп аталады, себебі ол кейбір гастроэнтерикалық көріністерден басқа алкогольмен мас болғандағы көріністер байқалады. Бас ауруы, бас айналу, құлақта шу, бұлшықеттік әлсіздік, аяқ қол дірілі байқалады. Сонымен бірге қарашықтын кенеюі, бет түсінің ционотикалығы, жүрістін бұзылуы және гастроэтерикалық көріністер байқалады. Айтылған барлық көріністер 2 тәуліктен кейін жоғалады. «Пьяный хлеб» улануының клиникалық көрінісі этиологиясы сияқты толық зерттелмеген.
2. Споротриеллотоксикоз (алиментарно-токсическая алейкия) - ауыр ауру, Fusarium sporotrichiella саңырауқұлағының микотоксиндер әсерімен байланысты.
Бұл ауру ерте көктем кезінде дамиды, бадамша безінің, жұмсақ таңдайдың және жұтқыншақтың артқы қабырғасын зақымдалумен сипатталады. Ауру аса маңызды емес продрамальды кезеннен басталады. Теріде полиморфты геморрагиялық бөртпелер пада болады, ал кейбір аймақтарда буллезді бөрпелер болады, оның құрамында серозды сұйықтық болады. Сол уақытта ауыз бен мұрынның шырышты қабығында ұсақ бөртпелер пайда болады. Жұмсақ таңдай бадамшасының гиперимиясынан кейін олардың үстінде некротикалық процесстер дамиды. Бірақ та аурудың сыртқы клиникалық симптомдардың пайда болуынеа дейін ең алғашқы белгісі қан құрамындағы өзгерістер болып табылады, ол гемопоэздің депрессиясын көрсетеді. Лейкоциттердін санының күрт төмендеуі, аурудың ауыр жағдайларында - 1 мм3 та 100-ге дейін және одан да төмен. Аурудын негізінде қанайналымнын бұзылуы нәтижесінде алейкия жатады. Бірақта уақытысында қолданған шаралар дың нәтижесінде сүйек кемігінің функциясын қалпына келтіру оның өмір сүргіштігін сақтауға мүмкіндік береді.
Патогенез сипатына байланысты ауруды алементарлы - токсикалық алейкия деп атайды. Саңырауқұлақ токсиндеріне үй жануарларының көбісі сезімтал келеді.
Алиментарлы - токсикалық алейкия ауруын алдын алу шараларына далада қыстап шыққан дәндерді қолданбау жатады. Профилактиканың қажетті шарты болып ақуыздарға және көмірсуларға бай тамақтану саналады.
Жануарлар септикалық ангинамен ауыратының ескеретің болсақ, онда қыста далада қалған дәндерді жануарларға жем ретінде қолданылуға болмайды. Көп жағдайда оларды спиртоводочный заводтарға спиртті өндіру үшін жібереді.
3. ( «пьянный хлеб» синдромы) - Fusarium graminearum-мен зақымдалған дәндерден пісірілген өнімдерді қолданғанда туындайтын ауру.

Бұл саңырауқұлақ ОЖЖ - ға әсер ететің, алколойдтарға және холиндерге, азотқұрамды глюкозидтерге жататын токсиндерді продуцирлейді. Бұл жағдайда әлсіздік, бастың ауруы, бастың айналуы, құсу, диарея, іш ауруы байқалады.
Психикалық бұзылыс пен анемия болуы мүмкін. Басқа Fusarium graminearum микотоксиндері - зеараленон - жемдерді қолданғанда, ірі қара мал мен шошқаларда вульвовагиниттерді, абортты, бесплодияны тудыруы мүмкін.
Фузарионивалетоксикоз «қызыл көгерумен» зақымдалған дәндерді қолданғанда туатын ауру. Бұл саңырауқұлақтар трихотецендер тобына Б типіне жататын ниваленон, фузаренон Х микотоксиндерін продуцирлейді.
Бери - бери ауруының жүректік формасы - Жапонияда 1700 жылдан белгілі ауру, Penicillium citreoviridae-мен зақымдалған сарғыш түсті күрішті тамаққа қолданғаннан туындайды.
Цитровиридин микотоксині орталық жүйке жүйесін және жүрек - қан тамыр жүйесін зақымдайды. Өлімге әкелуі мүмкін. P. Islandicum бауырды зақымдайтың исландитоксинді продуцирлейді.
Эрготизм - бұрыннан белгілі бүкіл әлемге белгілі ауру. Өткір формалары летальдықпен сипатталады. Ауру адамда өткір гастроэнтерит және ОЖЖ зақымдалу симптомдары байқалады. Созылмалы түрі құсумен, асқазан - ішек бұзылыстарымен сипатталады. Жыныс мүшелерінін зақымдалуы кезінде бесплодия болуы мүмкін.
Эрготизмнің 3 формасын ажыратады: конвульсивті, гангренозды, аралас. Эрготизмнің конвульсивті формасында бірінші орынға жүйке жүйесінін зақымдалуы тұрады: аяқ және қол саусақтарының парестезиясы, жансыздану, ұйқышандық; опистотонус, жақтың ұйуы болуы мүмкін, ал содан соң қол және аяқтың жазғыш бұлшық еттерінің контрактурасы, ОЖЖ зақымдалуы, естің бұзылыстары туады.
Гангренозды формасында бірінші орында жүрек - қан айналым жүйесінің бұзылуы тұрады: цианоз, қол мен аяқтың ауруы және басқа да симптомдар, қан тамырлардың облитерациясы нәтижесіндегі гангренаның көріністеріне ұқсас. Аурeдың патогенезінің мінезіне байланысты ауруды алиментарлы-токсикалық алейкия деп атайды. Саңырауқұлақтын токсиніне ұй жануарлардың көбісі сезімтал болып келеді. Тағамда F. Sporotrichiella токсины бар екенің тағам экстрактісін құстарға, мысықтарға, тышқандарға еңгізу арқылы анықтауға болады.
Ауыр жағдайда некроздың пайда болуымен гангрена дамиды. Споралардың алкалоидтары жұмсақ бұлшықеттерді, әсіресе жатырдың бұлшықетін қысқартатын қасиетке ие.
... жалғасы- Іс жүргізу
- Автоматтандыру, Техника
- Алғашқы әскери дайындық
- Астрономия
- Ауыл шаруашылығы
- Банк ісі
- Бизнесті бағалау
- Биология
- Бухгалтерлік іс
- Валеология
- Ветеринария
- География
- Геология, Геофизика, Геодезия
- Дін
- Ет, сүт, шарап өнімдері
- Жалпы тарих
- Жер кадастрі, Жылжымайтын мүлік
- Журналистика
- Информатика
- Кеден ісі
- Маркетинг
- Математика, Геометрия
- Медицина
- Мемлекеттік басқару
- Менеджмент
- Мұнай, Газ
- Мұрағат ісі
- Мәдениеттану
- ОБЖ (Основы безопасности жизнедеятельности)
- Педагогика
- Полиграфия
- Психология
- Салық
- Саясаттану
- Сақтандыру
- Сертификаттау, стандарттау
- Социология, Демография
- Спорт
- Статистика
- Тілтану, Филология
- Тарихи тұлғалар
- Тау-кен ісі
- Транспорт
- Туризм
- Физика
- Философия
- Халықаралық қатынастар
- Химия
- Экология, Қоршаған ортаны қорғау
- Экономика
- Экономикалық география
- Электротехника
- Қазақстан тарихы
- Қаржы
- Құрылыс
- Құқық, Криминалистика
- Әдебиет
- Өнер, музыка
- Өнеркәсіп, Өндіріс
Қазақ тілінде жазылған рефераттар, курстық жұмыстар, дипломдық жұмыстар бойынша біздің қор #1 болып табылады.



Ақпарат
Қосымша
Email: info@stud.kz